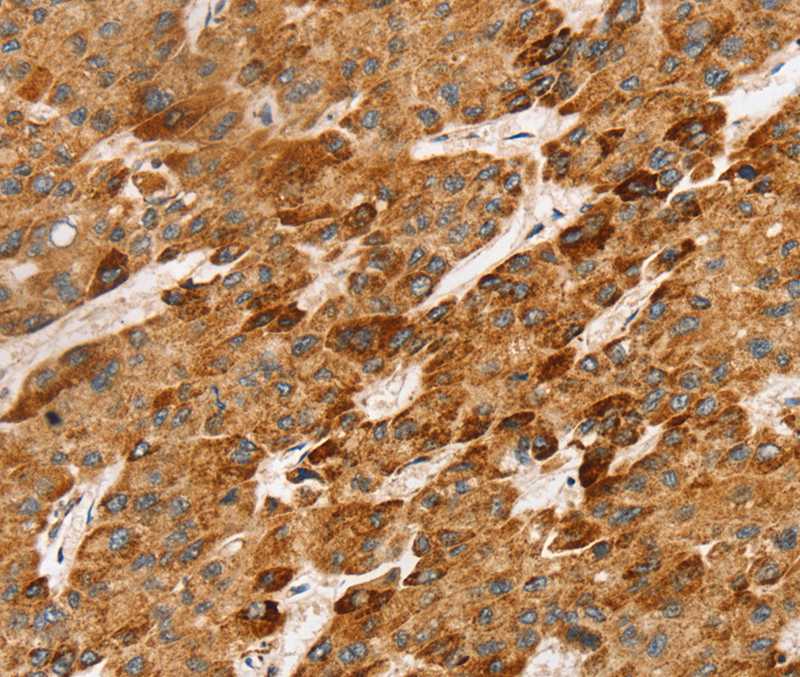
Anti-LTB Antibody

Lymphotoxin-Beta / LTB Antibody
LS-C814246
ApplicationsELISA, ImmunoHistoChemistry
Product group Antibodies
TargetLTB
Overview
- SupplierLifeSpan BioSciences
- Product NameLymphotoxin-Beta / LTB Antibody
- Delivery Days Customer14
- Application Supplier NoteApplications should be user optimized.
- ApplicationsELISA, ImmunoHistoChemistry
- Applications SupplierELISA (1:5000 - 1:20000), IHC Applications should be user optimized.
- CertificationResearch Use Only
- ClonalityPolyclonal
- ConjugateUnconjugated
- Estimated Purity...
- Gene ID4050
- Target nameLTB
- Target descriptionlymphotoxin beta
- Target synonymsTNFC, TNFSF3, TNLG1C, p33, lymphotoxin-beta, LT-beta, TNF superfamily member 3, TNF-C, lymphotoxin beta (TNF superfamily, member 3), tumor necrosis factor C, tumor necrosis factor ligand 1C, tumor necrosis factor ligand superfamily member 3
- HostRabbit
- IsotypeIgG
- Storage Instruction-20°C
- UNSPSC12352203